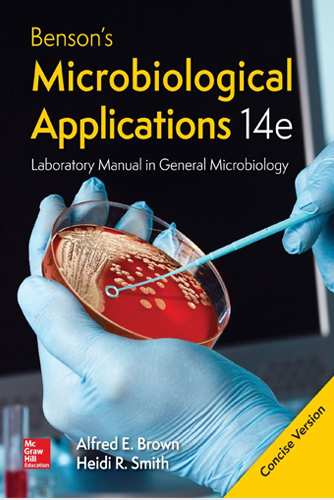

Feb 05, 2020
Welcome to LosAlamos Search Laboratory

Gene Editing and the Unthinkable Power to Control Evolution

Autophagy differentially regulates TNF receptor Fn14 by distinct mammalian Atg8 proteins

Energy, Evolution, and the Origins of Complex Life

The Microbes Within Us and a Grander View of Life

The Key to Understanding Disease, Chronic Illness, Aging, and Life Itself

How Tiny Creatures Manipulate Our Behavior and Shape Society

How Modern Biology Is Rewriting Our Understanding of Genetics, Disease, and Inheritance
LooseLeaf Benson's Microbiological Applications Laboratory Manual--Concise Version